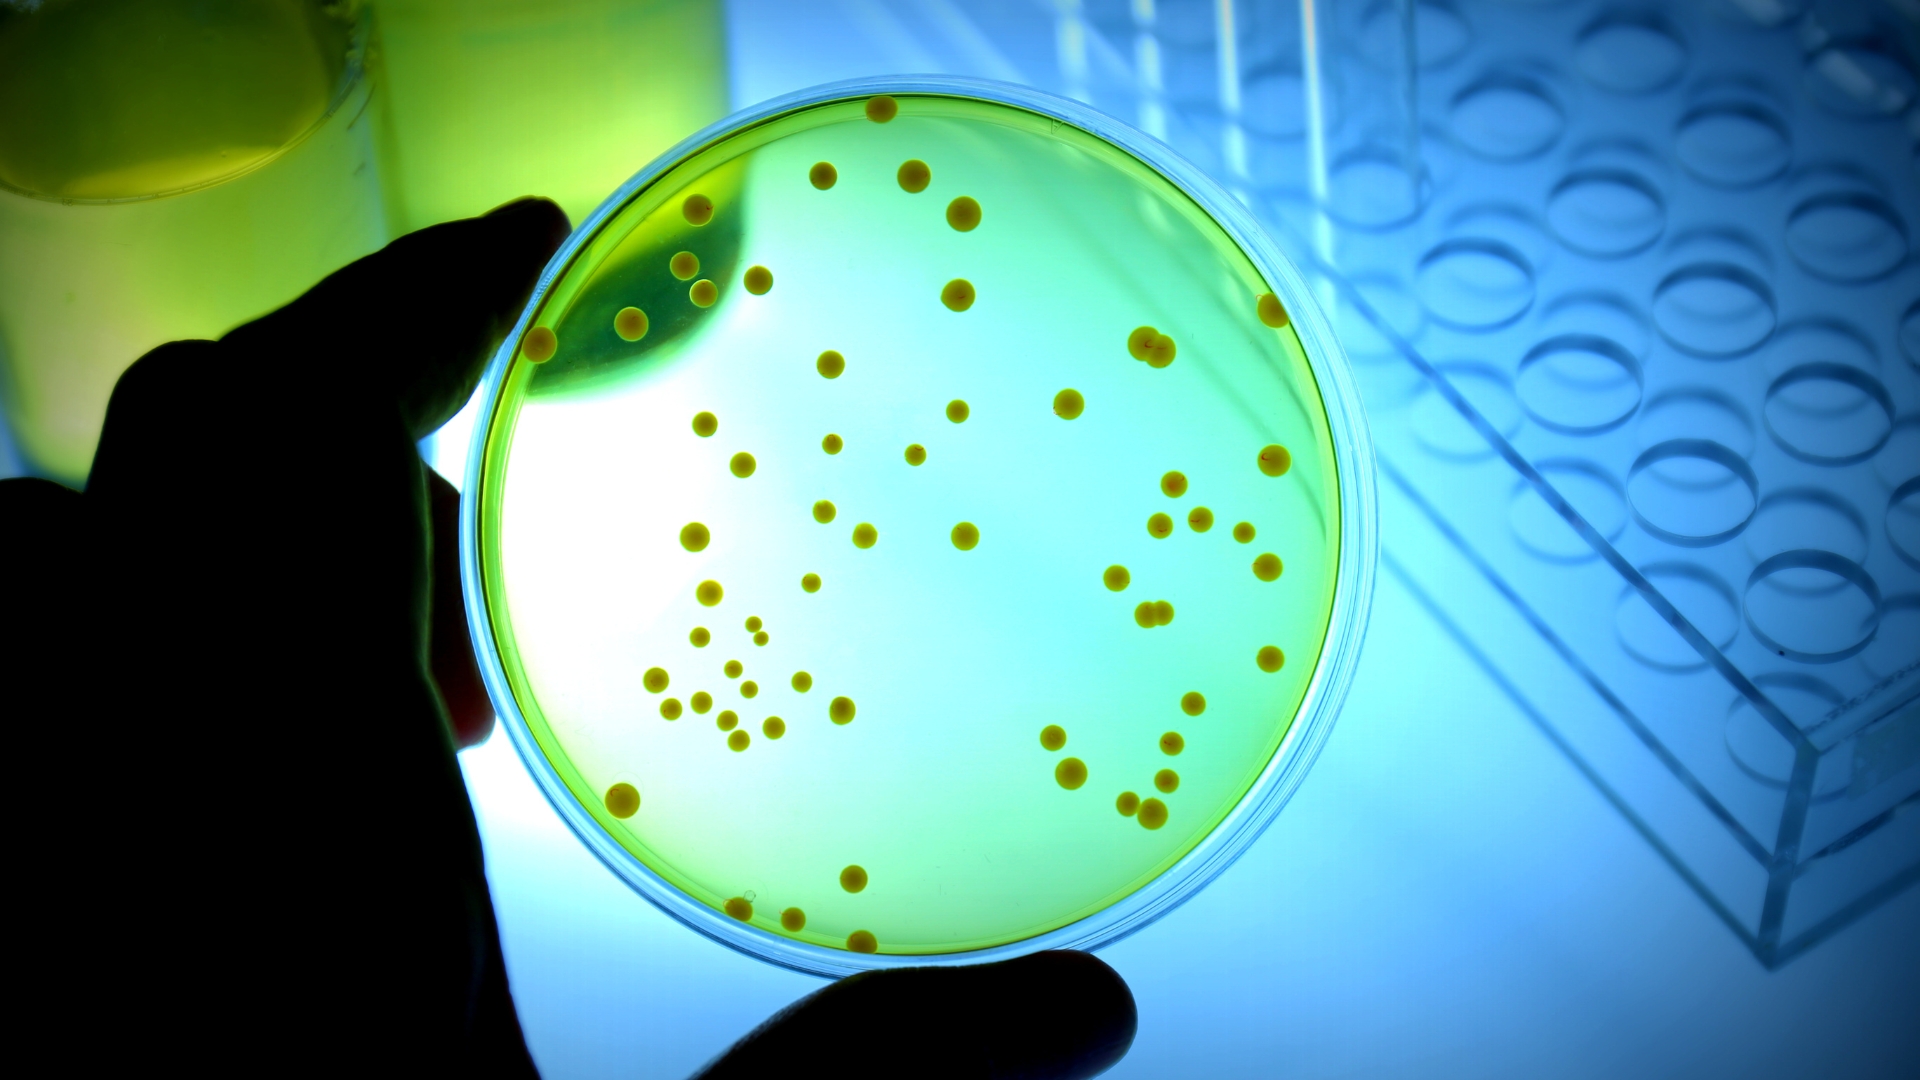

At Food Maven, we are committed to ensuring food safety, quality, and compliance with the highest industry standards. As a trusted food testing consultancy, we provide expert guidance to help businesses navigate regulatory requirements, detect contaminants, and maintain product integrity.
Let us help you protect your brand and build consumer trust with science-backed solutions.

Ensure the safety and quality of food and water with advanced testing methods. We analyze microbiological, chemical, and physical parameters to meet regulatory standards.
Parameters Tested:
✔️ Energy (Calories)
✔️ Protein, Carbohydrates, Fats
✔️ Sugar & Dietary Fiber
✔️ Sodium, Minerals & Vitamins
Methodology:
AOAC, FSSAI, ISO 22000 compliant testing
HPLC, Spectrophotometry, Gravimetric Analysis
Parameters Tested:
✔️ Organophosphates
✔️ Organochlorines
✔️ Carbamates
✔️ Pyrethroids
Methodology:
GCMS (Gas Chromatography Mass Spectrometry)
LCMS (Liquid Chromatography Mass Spectrometry)
Parameters Tested:
✔️ Lead (Pb)
✔️ Mercury (Hg)
✔️ Cadmium (Cd)
✔️ Arsenic (As)
Methodology:
ICPMS (Inductively Coupled Plasma Mass Spectrometry)
AAS (Atomic Absorption Spectroscopy)
Parameters Tested:
✔️ Calcium (Ca)
✔️ Magnesium (Mg)
✔️ Zinc (Zn)
✔️ Iron (Fe)
Methodology:
ICPMS, AAS, Spectrophotometry
Parameters Tested:
✔️ Aflatoxins (B1, B2, G1, G2)
✔️ Mycotoxins
✔️ Cyanotoxins
Methodology:
ELISA, HPLC, LCMS/MS
Parameters Tested:
✔️ Tetracyclines
✔️ Penicillin
✔️ Sulfonamides
Methodology:
LCMS/MS, HPLC
Food safety is not just a regulatory requirement—it’s a fundamental responsibility. Contaminated or poor-quality food can lead to serious health risks, legal penalties, and damage to a brand’s reputation. This is where food testing plays a crucial role.





+91 91595 90022
At Food Maven, we go beyond just testing—we provide expert guidance to help you maintain food safety, quality, and compliance with industry regulations.
Ensuring precision and credibility.
Quick turnaround time without compromising accuracy.
Professional guidance on test results and corrective actions.
At Food Maven, we understand the critical importance of food safety in today’s fastpaced food industry. Our stateoftheart food and water testing services are designed to ensure compliance with FSSAI, NABL, ISO, and HACCP standards, helping businesses maintain hygiene, quality, and regulatory compliance effortlessly.